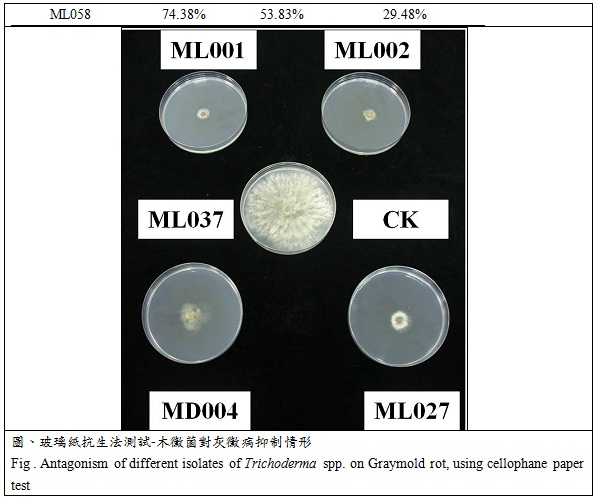
antagonism of different isolates of trichoderma spp on graymold rot using cellophane paper test

- Preliminary study on the major lepidopteran pests of Phyllanthus emblica in Taiwan
- Studies on establishment of health management system for major crops in Maioli area
- Studies on the antibateria for the control of organic rice seedling blight
- The research of strawberry seedling anthracnose and nonchemical management
- Studies of antagonistic yeast on preservation of organic orange fruit against postharvest diseases
- Development of an agricultural irrigation technology in Miaoli coastal sand area
- The crop quality and soil management at miaoli district
- Utilization of the technique of carbon dioxide on fertilization in fruits and vegetables under the protected cultivation
 Home > Recent Research > Crop Environment Division > The research of strawberry seedling anthracnose and nonchemical management Home > Recent Research > Crop Environment Division > The research of strawberry seedling anthracnose and nonchemical management
|
The research of strawberry seedling anthracnose and nonchemical management
Date:2014-07-15
We separated Trichoderma sp. from root with different soil pathogens in Miaoli county. Eighteen isolates were assayed in vitro for antagonism on the fungal pathogen of strawberry diseases, Phytophthora parasitica (Phytophthora fruit rot, ML036), Botrytis cinerea (Graymold rot, ML037), and Colletotrichum gloeosporioides (Anthracnose fruit rot, ML038), using cellophane paper method. Results showed that the mycelial suppressed rate of Phytophthora parasitica are 84-100%, Botrytis cinerea are 53.8-97%, and Colletotrichum gloeosporioides are 56.8-73.1%. For strawberry seedling anthracnose field test, ML001, ML031 and ML056 were chosen for biocontrol assay. After six weeks treatment, results showed that the disease rate of ML031 10 5 spore/ml was 5.56%, compared with control, the disease rate was decreased. The preliminary result showed that Trichoderma sp. could inhibit the crown rot of strawberry.